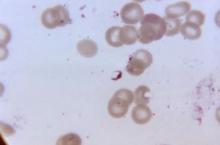

User login
Lucas Franki is an associate editor for MDedge News, and has been with the company since 2014. He has a BA in English from Penn State University and is an Eagle Scout.
Tapered approach better for discontinuing natalizumab in MS patients
A tapered approach to natalizumab discontinuation reduced the risk of multiple sclerosis (MS) relapse within 12 months of discontinuation, according to Dr. Bianca Weinstock-Guttman and her associates.
From a group of 50 patients with relapsing MS discontinuing natalizumab, 23 received two subsequent natalizumab infusions before beginning another disease-modifying therapy, while the remaining 27 began a new disease-modifying therapy immediately. In the tapered-discontinuation group, eight relapses were seen in the following 12 months, seven of which occurred within the first 3 months. In the immediate-discontinuation group, 28 relapses were seen, 20 of which occurred within 3 months.
A higher number of new T2 lesions were seen in the immediate-discontinuation group, compared with the tapered group, as well as a higher mean T2 lesion volume change after 12 months, and a higher number of new T1 hypointense lesions.
“Receptor saturation may be more relevant to natalizumab effectiveness than natalizumab serum concentration. Based on our study, we postulate that tapering the infusions, instead of immediate discontinuation, may provide a slower rate for VLA4 desaturation that may be of clinical importance,” the investigators noted.
Find the full study in the Journal of Neurology, Neurosurgery & Psychiatry (doi: 10.1136/jnnp-2015-312221).
A tapered approach to natalizumab discontinuation reduced the risk of multiple sclerosis (MS) relapse within 12 months of discontinuation, according to Dr. Bianca Weinstock-Guttman and her associates.
From a group of 50 patients with relapsing MS discontinuing natalizumab, 23 received two subsequent natalizumab infusions before beginning another disease-modifying therapy, while the remaining 27 began a new disease-modifying therapy immediately. In the tapered-discontinuation group, eight relapses were seen in the following 12 months, seven of which occurred within the first 3 months. In the immediate-discontinuation group, 28 relapses were seen, 20 of which occurred within 3 months.
A higher number of new T2 lesions were seen in the immediate-discontinuation group, compared with the tapered group, as well as a higher mean T2 lesion volume change after 12 months, and a higher number of new T1 hypointense lesions.
“Receptor saturation may be more relevant to natalizumab effectiveness than natalizumab serum concentration. Based on our study, we postulate that tapering the infusions, instead of immediate discontinuation, may provide a slower rate for VLA4 desaturation that may be of clinical importance,” the investigators noted.
Find the full study in the Journal of Neurology, Neurosurgery & Psychiatry (doi: 10.1136/jnnp-2015-312221).
A tapered approach to natalizumab discontinuation reduced the risk of multiple sclerosis (MS) relapse within 12 months of discontinuation, according to Dr. Bianca Weinstock-Guttman and her associates.
From a group of 50 patients with relapsing MS discontinuing natalizumab, 23 received two subsequent natalizumab infusions before beginning another disease-modifying therapy, while the remaining 27 began a new disease-modifying therapy immediately. In the tapered-discontinuation group, eight relapses were seen in the following 12 months, seven of which occurred within the first 3 months. In the immediate-discontinuation group, 28 relapses were seen, 20 of which occurred within 3 months.
A higher number of new T2 lesions were seen in the immediate-discontinuation group, compared with the tapered group, as well as a higher mean T2 lesion volume change after 12 months, and a higher number of new T1 hypointense lesions.
“Receptor saturation may be more relevant to natalizumab effectiveness than natalizumab serum concentration. Based on our study, we postulate that tapering the infusions, instead of immediate discontinuation, may provide a slower rate for VLA4 desaturation that may be of clinical importance,” the investigators noted.
Find the full study in the Journal of Neurology, Neurosurgery & Psychiatry (doi: 10.1136/jnnp-2015-312221).
FROM THE JOURNAL OF NEUROLOGY, NEUROSURGERY & PSYCHIATRY
For HIV PrEP, FTC-TDF as safe as aspirin
The combination oral therapeutic emtricitabine-tenofovir disoproxil fumarate (FTC-TDF) for pre-exposure prophylaxis (PrEP) for HIV infection compares favorably to aspirin in terms of user safety, according to a review by researchers at the David Geffen School of Medicine, University of California Los Angeles.
For the review, Dr. Noah Kojima and Dr. Jeffrey Klausner assessed five major studies on PrEP for HIV infection. The numbers needed to harm (NNH) were calculated for FTC-TDF for HIV infection PrEP and aspirin usage. For FTC-TDF PrEP, the NNH in homosexual men and transexual women was 1 case per 114 person-years for nausea and 96 person-years for unintentional weight loss. In heterosexual couples, the NNH was 68 person-years for moderate decreased neutrophil count.
For aspirin, the NNH for any bleeding problem was 15 person-years, 123 person-years for any gastrointestinal bleeding, and 909 for major gastrointestinal bleeding in men. In women, the NNH for easy bruising was 10 person-years.
While researchers acknowledged that long-term studies are needed, it appears FTC-TDF for PrEP for HIV infection favorably compares to aspirin in terms of user safety.
“Given the observed safety and efficacy of FTC-TDF for PrEP for HIV infection and intent of the majority of high-risk MSM to use PrEP, physicians should now actively look for patients who may benefit from it. A ‘duty to prevent’ suggests that physicians should identify patients in their practice with behaviors that might put them at risk for HIV infection and offer PrEP routinely,” the investigators concluded.
Find the full study in Open Forum Infectious Diseases (doi: 10.1093/ofid/ofv221).
The combination oral therapeutic emtricitabine-tenofovir disoproxil fumarate (FTC-TDF) for pre-exposure prophylaxis (PrEP) for HIV infection compares favorably to aspirin in terms of user safety, according to a review by researchers at the David Geffen School of Medicine, University of California Los Angeles.
For the review, Dr. Noah Kojima and Dr. Jeffrey Klausner assessed five major studies on PrEP for HIV infection. The numbers needed to harm (NNH) were calculated for FTC-TDF for HIV infection PrEP and aspirin usage. For FTC-TDF PrEP, the NNH in homosexual men and transexual women was 1 case per 114 person-years for nausea and 96 person-years for unintentional weight loss. In heterosexual couples, the NNH was 68 person-years for moderate decreased neutrophil count.
For aspirin, the NNH for any bleeding problem was 15 person-years, 123 person-years for any gastrointestinal bleeding, and 909 for major gastrointestinal bleeding in men. In women, the NNH for easy bruising was 10 person-years.
While researchers acknowledged that long-term studies are needed, it appears FTC-TDF for PrEP for HIV infection favorably compares to aspirin in terms of user safety.
“Given the observed safety and efficacy of FTC-TDF for PrEP for HIV infection and intent of the majority of high-risk MSM to use PrEP, physicians should now actively look for patients who may benefit from it. A ‘duty to prevent’ suggests that physicians should identify patients in their practice with behaviors that might put them at risk for HIV infection and offer PrEP routinely,” the investigators concluded.
Find the full study in Open Forum Infectious Diseases (doi: 10.1093/ofid/ofv221).
The combination oral therapeutic emtricitabine-tenofovir disoproxil fumarate (FTC-TDF) for pre-exposure prophylaxis (PrEP) for HIV infection compares favorably to aspirin in terms of user safety, according to a review by researchers at the David Geffen School of Medicine, University of California Los Angeles.
For the review, Dr. Noah Kojima and Dr. Jeffrey Klausner assessed five major studies on PrEP for HIV infection. The numbers needed to harm (NNH) were calculated for FTC-TDF for HIV infection PrEP and aspirin usage. For FTC-TDF PrEP, the NNH in homosexual men and transexual women was 1 case per 114 person-years for nausea and 96 person-years for unintentional weight loss. In heterosexual couples, the NNH was 68 person-years for moderate decreased neutrophil count.
For aspirin, the NNH for any bleeding problem was 15 person-years, 123 person-years for any gastrointestinal bleeding, and 909 for major gastrointestinal bleeding in men. In women, the NNH for easy bruising was 10 person-years.
While researchers acknowledged that long-term studies are needed, it appears FTC-TDF for PrEP for HIV infection favorably compares to aspirin in terms of user safety.
“Given the observed safety and efficacy of FTC-TDF for PrEP for HIV infection and intent of the majority of high-risk MSM to use PrEP, physicians should now actively look for patients who may benefit from it. A ‘duty to prevent’ suggests that physicians should identify patients in their practice with behaviors that might put them at risk for HIV infection and offer PrEP routinely,” the investigators concluded.
Find the full study in Open Forum Infectious Diseases (doi: 10.1093/ofid/ofv221).
FROM OPEN FORUM INFECTIOUS DISEASES
Cortical thickness, symptom insight related in schizophrenia
Schizophrenia patients with less insight into their symptoms had thinner cortical thickness in the right insular cortex than did patients with greater insight, according to Seema Emami and associates.
Ms. Emami recruited 67 patients aged 18-50 with schizophrenia from clinics at the Douglas Mental Health University Institute in Montreal. The patients were assessed using two instruments – the Scale for Assessment of Positive Symptoms and the Scale for the Assessment of Insight – Expanded. Cortical thickness data were assessed using MRI.
Compared with a healthy control group, schizophrenia patients with less insight into symptoms (IS) had thinner right insular cortex than patients with greater IS. Patients with greater IS showed “cortical thickness differences only in the right inferior temporal cortex and right anterior cingulate gyrus,” the investigators wrote.
No difference between patient groups was found in the frontal lobe region or the superior temporal gyrus on either hemisphere. Small correlations were observed between illness insight and thinner cortex in the right parahippocampal gyrus, and in awareness of need for treatment and thinner cortex in the left cuneus and right parahippocampal gyrus.
“Better measurement and understanding of symptom awareness, as well as development of insight remediation therapies, may aid clinicians in improving therapeutic cooperation and contribute to reduced treatment noncompliance,” the investigators noted.
Find the full study in Schizophrenia Research (doi: 10.1016/j.schres.2015.10.016).
Schizophrenia patients with less insight into their symptoms had thinner cortical thickness in the right insular cortex than did patients with greater insight, according to Seema Emami and associates.
Ms. Emami recruited 67 patients aged 18-50 with schizophrenia from clinics at the Douglas Mental Health University Institute in Montreal. The patients were assessed using two instruments – the Scale for Assessment of Positive Symptoms and the Scale for the Assessment of Insight – Expanded. Cortical thickness data were assessed using MRI.
Compared with a healthy control group, schizophrenia patients with less insight into symptoms (IS) had thinner right insular cortex than patients with greater IS. Patients with greater IS showed “cortical thickness differences only in the right inferior temporal cortex and right anterior cingulate gyrus,” the investigators wrote.
No difference between patient groups was found in the frontal lobe region or the superior temporal gyrus on either hemisphere. Small correlations were observed between illness insight and thinner cortex in the right parahippocampal gyrus, and in awareness of need for treatment and thinner cortex in the left cuneus and right parahippocampal gyrus.
“Better measurement and understanding of symptom awareness, as well as development of insight remediation therapies, may aid clinicians in improving therapeutic cooperation and contribute to reduced treatment noncompliance,” the investigators noted.
Find the full study in Schizophrenia Research (doi: 10.1016/j.schres.2015.10.016).
Schizophrenia patients with less insight into their symptoms had thinner cortical thickness in the right insular cortex than did patients with greater insight, according to Seema Emami and associates.
Ms. Emami recruited 67 patients aged 18-50 with schizophrenia from clinics at the Douglas Mental Health University Institute in Montreal. The patients were assessed using two instruments – the Scale for Assessment of Positive Symptoms and the Scale for the Assessment of Insight – Expanded. Cortical thickness data were assessed using MRI.
Compared with a healthy control group, schizophrenia patients with less insight into symptoms (IS) had thinner right insular cortex than patients with greater IS. Patients with greater IS showed “cortical thickness differences only in the right inferior temporal cortex and right anterior cingulate gyrus,” the investigators wrote.
No difference between patient groups was found in the frontal lobe region or the superior temporal gyrus on either hemisphere. Small correlations were observed between illness insight and thinner cortex in the right parahippocampal gyrus, and in awareness of need for treatment and thinner cortex in the left cuneus and right parahippocampal gyrus.
“Better measurement and understanding of symptom awareness, as well as development of insight remediation therapies, may aid clinicians in improving therapeutic cooperation and contribute to reduced treatment noncompliance,” the investigators noted.
Find the full study in Schizophrenia Research (doi: 10.1016/j.schres.2015.10.016).
FROM SCHIZOPHRENIA RESEARCH
Less severe schizophrenia linked to positive employment outcomes
Schizophrenia patients with more satisfying employment status have better subjective quality of life and functional capacity, according to Haruo Fujino and associates.
For the study, 93 schizophrenia patients received an extensive battery of cognitive tests. The results were evaluated using a model predicting employment status, with negative symptoms and poor functional capacity predicting poor employment status. Positive symptoms did not influence employment status, reported Mr. Fujino of Osaka (Japan) University.
A second model that incorporated quality of life (QOL) assessments found similar results to the first model, where poorer subjective QOL was related to negative emotions and worse employment status. Both models satisfied good fit criteria.
“The role of functional capacity may be important for the employment/occupation domain of social functioning in patients with schizophrenia, as poor cognitive abilities may underlie the deficit patients present in their ability to perform daily activities, which leads to inefficiency in work life. These findings suggest an important role of functional capacity as a link between cognitive improvement and employment outcomes,” the investigators wrote.
Find the full study in Schizophrenia Research: Cognition (doi: 10.1016/j.scog.2015.10.005).
Schizophrenia patients with more satisfying employment status have better subjective quality of life and functional capacity, according to Haruo Fujino and associates.
For the study, 93 schizophrenia patients received an extensive battery of cognitive tests. The results were evaluated using a model predicting employment status, with negative symptoms and poor functional capacity predicting poor employment status. Positive symptoms did not influence employment status, reported Mr. Fujino of Osaka (Japan) University.
A second model that incorporated quality of life (QOL) assessments found similar results to the first model, where poorer subjective QOL was related to negative emotions and worse employment status. Both models satisfied good fit criteria.
“The role of functional capacity may be important for the employment/occupation domain of social functioning in patients with schizophrenia, as poor cognitive abilities may underlie the deficit patients present in their ability to perform daily activities, which leads to inefficiency in work life. These findings suggest an important role of functional capacity as a link between cognitive improvement and employment outcomes,” the investigators wrote.
Find the full study in Schizophrenia Research: Cognition (doi: 10.1016/j.scog.2015.10.005).
Schizophrenia patients with more satisfying employment status have better subjective quality of life and functional capacity, according to Haruo Fujino and associates.
For the study, 93 schizophrenia patients received an extensive battery of cognitive tests. The results were evaluated using a model predicting employment status, with negative symptoms and poor functional capacity predicting poor employment status. Positive symptoms did not influence employment status, reported Mr. Fujino of Osaka (Japan) University.
A second model that incorporated quality of life (QOL) assessments found similar results to the first model, where poorer subjective QOL was related to negative emotions and worse employment status. Both models satisfied good fit criteria.
“The role of functional capacity may be important for the employment/occupation domain of social functioning in patients with schizophrenia, as poor cognitive abilities may underlie the deficit patients present in their ability to perform daily activities, which leads to inefficiency in work life. These findings suggest an important role of functional capacity as a link between cognitive improvement and employment outcomes,” the investigators wrote.
Find the full study in Schizophrenia Research: Cognition (doi: 10.1016/j.scog.2015.10.005).
FROM SCHIZOPHRENIA RESEARCH: COGNITION
Meningococcal conjugate vaccine safe, effective with other vaccines
The quadrivalent meningococcal conjugate vaccine MenACWY-CRM can be safely coadministered with other routine vaccines in all age groups, according to Dr. Roberto Gasparini of the University of Genoa, Italy, and his associates.
Infant immune response to diphtheria, tetanus, poliovirus, hepatitis B, Haemophilus influenzae type b, pneumococcal conjugate, measles-mumps-rubella, varicella or pertussis antigens was unaffected by coadministered MenACWY-CRM. In some infants under 7 months old, noninferiority criteria were not met for some pneumococcal serotypes, but no consistent pattern was seen.
In adolescents, a concurrent MenACWY-CRM vaccination did not adversely affect immune responses to tetanus, diphtheria, and human papillomavirus antigens. In adults, the MenACWY-CRM vaccine did not affect immune response to hepatitis A/B, typhoid fever, yellow fever, Japanese encephalitis, and rabies antigens. No group saw an increase in postvaccination adverse events.
“These findings support the concomitant administration of MenACWY-CRM with routine vaccines in all age groups, allowing MenACWY-CRM to be readily incorporated as recommended into existing infant and adolescent vaccination schedules and to be administered with other vaccines as needed in advance of international travel,” the investigators concluded.
Find the full study in the Pediatric Infectious Disease Journal (2016;35[1]:81-93. doi: 10.1097/INF.0000000000000930).
The quadrivalent meningococcal conjugate vaccine MenACWY-CRM can be safely coadministered with other routine vaccines in all age groups, according to Dr. Roberto Gasparini of the University of Genoa, Italy, and his associates.
Infant immune response to diphtheria, tetanus, poliovirus, hepatitis B, Haemophilus influenzae type b, pneumococcal conjugate, measles-mumps-rubella, varicella or pertussis antigens was unaffected by coadministered MenACWY-CRM. In some infants under 7 months old, noninferiority criteria were not met for some pneumococcal serotypes, but no consistent pattern was seen.
In adolescents, a concurrent MenACWY-CRM vaccination did not adversely affect immune responses to tetanus, diphtheria, and human papillomavirus antigens. In adults, the MenACWY-CRM vaccine did not affect immune response to hepatitis A/B, typhoid fever, yellow fever, Japanese encephalitis, and rabies antigens. No group saw an increase in postvaccination adverse events.
“These findings support the concomitant administration of MenACWY-CRM with routine vaccines in all age groups, allowing MenACWY-CRM to be readily incorporated as recommended into existing infant and adolescent vaccination schedules and to be administered with other vaccines as needed in advance of international travel,” the investigators concluded.
Find the full study in the Pediatric Infectious Disease Journal (2016;35[1]:81-93. doi: 10.1097/INF.0000000000000930).
The quadrivalent meningococcal conjugate vaccine MenACWY-CRM can be safely coadministered with other routine vaccines in all age groups, according to Dr. Roberto Gasparini of the University of Genoa, Italy, and his associates.
Infant immune response to diphtheria, tetanus, poliovirus, hepatitis B, Haemophilus influenzae type b, pneumococcal conjugate, measles-mumps-rubella, varicella or pertussis antigens was unaffected by coadministered MenACWY-CRM. In some infants under 7 months old, noninferiority criteria were not met for some pneumococcal serotypes, but no consistent pattern was seen.
In adolescents, a concurrent MenACWY-CRM vaccination did not adversely affect immune responses to tetanus, diphtheria, and human papillomavirus antigens. In adults, the MenACWY-CRM vaccine did not affect immune response to hepatitis A/B, typhoid fever, yellow fever, Japanese encephalitis, and rabies antigens. No group saw an increase in postvaccination adverse events.
“These findings support the concomitant administration of MenACWY-CRM with routine vaccines in all age groups, allowing MenACWY-CRM to be readily incorporated as recommended into existing infant and adolescent vaccination schedules and to be administered with other vaccines as needed in advance of international travel,” the investigators concluded.
Find the full study in the Pediatric Infectious Disease Journal (2016;35[1]:81-93. doi: 10.1097/INF.0000000000000930).
FROM THE PEDIATRIC INFECTIOUS DISEASE JOURNAL
Hawaii healthiest U.S. state in 2015, North Carolina most improved
For the fourth year in a row, Hawaii was named the healthiest state in America by the United Health Foundation in the 2015 edition of “America’s Health Rankings.”
A low obesity prevalence, low rate of preventable hospitalizations, few poor mental health days, and an 11% increase in immunization among children aged 19-35 months in 2015 helped make Hawaii the healthiest state over second-ranked Vermont. Massachusetts ranked third, with Minnesota and New Hampshire rounding out the top five.

At the other end of the list, Louisiana replaced Mississippi as the least healthy state in 2015. Mississippi rose by one spot to 49th, however, followed by Arkansas at 48th, West Virginia at 47th, and Alabama at 46th.
The most improved state for 2015 was North Carolina, moving six spots up from 37th to 31st. Other states that saw significant moves upward were Maine, Washington, Delaware, and Kentucky. The largest decline was by Oregon, which dropped eight spots to 20th from 12th. New Mexico, Alabama, North Dakota, Texas, and West Virginia also made considerable downward movements.
Overall, the United States saw a significant decrease in preventable hospitalizations, physical inactivity, smoking, cardiovascular deaths, and infant mortality, and an increase in recommended vaccination coverage. Obesity rates increased, however, as did diabetes rates, drug deaths, and children living in poverty, and no progress was made in reducing premature deaths.
“America’s Health Rankings” is a joint effort by the United Health Foundation and the American Public Health Association. It is funded entirely by the private, not-for-profit United Health Foundation, founded by UnitedHealth Group, which operates UnitedHealthcare.
For the fourth year in a row, Hawaii was named the healthiest state in America by the United Health Foundation in the 2015 edition of “America’s Health Rankings.”
A low obesity prevalence, low rate of preventable hospitalizations, few poor mental health days, and an 11% increase in immunization among children aged 19-35 months in 2015 helped make Hawaii the healthiest state over second-ranked Vermont. Massachusetts ranked third, with Minnesota and New Hampshire rounding out the top five.

At the other end of the list, Louisiana replaced Mississippi as the least healthy state in 2015. Mississippi rose by one spot to 49th, however, followed by Arkansas at 48th, West Virginia at 47th, and Alabama at 46th.
The most improved state for 2015 was North Carolina, moving six spots up from 37th to 31st. Other states that saw significant moves upward were Maine, Washington, Delaware, and Kentucky. The largest decline was by Oregon, which dropped eight spots to 20th from 12th. New Mexico, Alabama, North Dakota, Texas, and West Virginia also made considerable downward movements.
Overall, the United States saw a significant decrease in preventable hospitalizations, physical inactivity, smoking, cardiovascular deaths, and infant mortality, and an increase in recommended vaccination coverage. Obesity rates increased, however, as did diabetes rates, drug deaths, and children living in poverty, and no progress was made in reducing premature deaths.
“America’s Health Rankings” is a joint effort by the United Health Foundation and the American Public Health Association. It is funded entirely by the private, not-for-profit United Health Foundation, founded by UnitedHealth Group, which operates UnitedHealthcare.
For the fourth year in a row, Hawaii was named the healthiest state in America by the United Health Foundation in the 2015 edition of “America’s Health Rankings.”
A low obesity prevalence, low rate of preventable hospitalizations, few poor mental health days, and an 11% increase in immunization among children aged 19-35 months in 2015 helped make Hawaii the healthiest state over second-ranked Vermont. Massachusetts ranked third, with Minnesota and New Hampshire rounding out the top five.

At the other end of the list, Louisiana replaced Mississippi as the least healthy state in 2015. Mississippi rose by one spot to 49th, however, followed by Arkansas at 48th, West Virginia at 47th, and Alabama at 46th.
The most improved state for 2015 was North Carolina, moving six spots up from 37th to 31st. Other states that saw significant moves upward were Maine, Washington, Delaware, and Kentucky. The largest decline was by Oregon, which dropped eight spots to 20th from 12th. New Mexico, Alabama, North Dakota, Texas, and West Virginia also made considerable downward movements.
Overall, the United States saw a significant decrease in preventable hospitalizations, physical inactivity, smoking, cardiovascular deaths, and infant mortality, and an increase in recommended vaccination coverage. Obesity rates increased, however, as did diabetes rates, drug deaths, and children living in poverty, and no progress was made in reducing premature deaths.
“America’s Health Rankings” is a joint effort by the United Health Foundation and the American Public Health Association. It is funded entirely by the private, not-for-profit United Health Foundation, founded by UnitedHealth Group, which operates UnitedHealthcare.
Increased heroin use may not be linked to rise in prescription opioid use
The increase in nonmedical prescription opioid use in the United States does not appear to be strongly related to the concurrent increase in heroin use, according to a review by Dr. Wilson Compton of the National Institute on Drug Abuse, Bethesda, Md., and his associates.
While heroin users are 3.9 times more likely to have used nonmedical prescription opioids than are those who haven’t used heroin, heroin use only occurs in a small number of nonmedical prescription opioid users. The researchers cited studies showing that 3.6% of opioid users began using heroin within 5 years of beginning opioid use, and 4.2% of opioid users reported also using heroin in the past year.
A more likely driver for the increased use of heroin and heroin death rate is decreased cost and increased availability, the investigators wrote. For every $100 decrease in price per gram of heroin, hospitalizations for heroin overdose increase by 2.9%. In addition, heroin use has grown significantly in areas of the United States that were not typically centers for heroin distribution, the researchers reported.
“Fundamentally, prescription opioids and heroin are each elements of a larger epidemic of opioid-related disorders and death. Viewing them from a unified perspective is essential to improving public health. The perniciousness of this epidemic requires a multipronged interventional approach that engages all sectors of society,” the investigators wrote.
Dr. Compton has ties with General Electric, 3M, and Pfizer. No other conflicts were reported. Find the study in the New England Journal of Medicine (doi: 10.1056/NEJMra1508490).
The increase in nonmedical prescription opioid use in the United States does not appear to be strongly related to the concurrent increase in heroin use, according to a review by Dr. Wilson Compton of the National Institute on Drug Abuse, Bethesda, Md., and his associates.
While heroin users are 3.9 times more likely to have used nonmedical prescription opioids than are those who haven’t used heroin, heroin use only occurs in a small number of nonmedical prescription opioid users. The researchers cited studies showing that 3.6% of opioid users began using heroin within 5 years of beginning opioid use, and 4.2% of opioid users reported also using heroin in the past year.
A more likely driver for the increased use of heroin and heroin death rate is decreased cost and increased availability, the investigators wrote. For every $100 decrease in price per gram of heroin, hospitalizations for heroin overdose increase by 2.9%. In addition, heroin use has grown significantly in areas of the United States that were not typically centers for heroin distribution, the researchers reported.
“Fundamentally, prescription opioids and heroin are each elements of a larger epidemic of opioid-related disorders and death. Viewing them from a unified perspective is essential to improving public health. The perniciousness of this epidemic requires a multipronged interventional approach that engages all sectors of society,” the investigators wrote.
Dr. Compton has ties with General Electric, 3M, and Pfizer. No other conflicts were reported. Find the study in the New England Journal of Medicine (doi: 10.1056/NEJMra1508490).
The increase in nonmedical prescription opioid use in the United States does not appear to be strongly related to the concurrent increase in heroin use, according to a review by Dr. Wilson Compton of the National Institute on Drug Abuse, Bethesda, Md., and his associates.
While heroin users are 3.9 times more likely to have used nonmedical prescription opioids than are those who haven’t used heroin, heroin use only occurs in a small number of nonmedical prescription opioid users. The researchers cited studies showing that 3.6% of opioid users began using heroin within 5 years of beginning opioid use, and 4.2% of opioid users reported also using heroin in the past year.
A more likely driver for the increased use of heroin and heroin death rate is decreased cost and increased availability, the investigators wrote. For every $100 decrease in price per gram of heroin, hospitalizations for heroin overdose increase by 2.9%. In addition, heroin use has grown significantly in areas of the United States that were not typically centers for heroin distribution, the researchers reported.
“Fundamentally, prescription opioids and heroin are each elements of a larger epidemic of opioid-related disorders and death. Viewing them from a unified perspective is essential to improving public health. The perniciousness of this epidemic requires a multipronged interventional approach that engages all sectors of society,” the investigators wrote.
Dr. Compton has ties with General Electric, 3M, and Pfizer. No other conflicts were reported. Find the study in the New England Journal of Medicine (doi: 10.1056/NEJMra1508490).
FROM THE NEW ENGLAND JOURNAL OF MEDICINE
Corneal confocal microscopy deemed useful in immune-mediated neuropathies
Corneal confocal microscopy was effective at identifying and diagnosing subsets of chronic inflammatory demyelinating polyradiculoneuropathy and multifocal motor neuropathy, according to Dr. Mark Stettner and his associates.
The investigators used corneal confocal microscopy (CCM) to show that measurements of corneal nerve fiber properties including overall density, branch density, and length, were reduced and immune cell infiltration was increased in 88 patients with chronic inflammatory demyelinating polyradiculoneuropathy (CIDP) and 6 with multifocal motor neuropathy (MMN), compared with 88 healthy controls.
The number of dendritic cells with corneal nerve fiber contacts rose significantly along with the duration of disease, starting with comparisons of durations of less than 1 year versus greater than 1 year. Patients without motor disability had significantly lower values for corneal nerve fiber length and density than did those with slight motor disability, but this did not correlate with the degree of severity and was limited to the lower extremities. Corneal nerve fiber density and length were further reduced and nondendritic cells were increased in patients with painful neuropathy, compared with painless neuropathy. CIDP patients with antineuronal antibodies also had increased nondendritic cells, but the number of cells in proximity to corneal nerve fibers did not differ according to antibody status, the investigators found.
“While the characterization of cells into dendritic and nondendritic cells based on the morphological criteria should be interpreted with caution, it may provide insights into the underlying pathophysiology. CCM may be a useful technique in the diagnosis and management of patients with inflammatory neuropathy and this warrants further studies,” the investigators concluded.
Find the full study in Annals of Clinical and Translational Neurology (doi: 10.1002/acn3.275).
Corneal confocal microscopy was effective at identifying and diagnosing subsets of chronic inflammatory demyelinating polyradiculoneuropathy and multifocal motor neuropathy, according to Dr. Mark Stettner and his associates.
The investigators used corneal confocal microscopy (CCM) to show that measurements of corneal nerve fiber properties including overall density, branch density, and length, were reduced and immune cell infiltration was increased in 88 patients with chronic inflammatory demyelinating polyradiculoneuropathy (CIDP) and 6 with multifocal motor neuropathy (MMN), compared with 88 healthy controls.
The number of dendritic cells with corneal nerve fiber contacts rose significantly along with the duration of disease, starting with comparisons of durations of less than 1 year versus greater than 1 year. Patients without motor disability had significantly lower values for corneal nerve fiber length and density than did those with slight motor disability, but this did not correlate with the degree of severity and was limited to the lower extremities. Corneal nerve fiber density and length were further reduced and nondendritic cells were increased in patients with painful neuropathy, compared with painless neuropathy. CIDP patients with antineuronal antibodies also had increased nondendritic cells, but the number of cells in proximity to corneal nerve fibers did not differ according to antibody status, the investigators found.
“While the characterization of cells into dendritic and nondendritic cells based on the morphological criteria should be interpreted with caution, it may provide insights into the underlying pathophysiology. CCM may be a useful technique in the diagnosis and management of patients with inflammatory neuropathy and this warrants further studies,” the investigators concluded.
Find the full study in Annals of Clinical and Translational Neurology (doi: 10.1002/acn3.275).
Corneal confocal microscopy was effective at identifying and diagnosing subsets of chronic inflammatory demyelinating polyradiculoneuropathy and multifocal motor neuropathy, according to Dr. Mark Stettner and his associates.
The investigators used corneal confocal microscopy (CCM) to show that measurements of corneal nerve fiber properties including overall density, branch density, and length, were reduced and immune cell infiltration was increased in 88 patients with chronic inflammatory demyelinating polyradiculoneuropathy (CIDP) and 6 with multifocal motor neuropathy (MMN), compared with 88 healthy controls.
The number of dendritic cells with corneal nerve fiber contacts rose significantly along with the duration of disease, starting with comparisons of durations of less than 1 year versus greater than 1 year. Patients without motor disability had significantly lower values for corneal nerve fiber length and density than did those with slight motor disability, but this did not correlate with the degree of severity and was limited to the lower extremities. Corneal nerve fiber density and length were further reduced and nondendritic cells were increased in patients with painful neuropathy, compared with painless neuropathy. CIDP patients with antineuronal antibodies also had increased nondendritic cells, but the number of cells in proximity to corneal nerve fibers did not differ according to antibody status, the investigators found.
“While the characterization of cells into dendritic and nondendritic cells based on the morphological criteria should be interpreted with caution, it may provide insights into the underlying pathophysiology. CCM may be a useful technique in the diagnosis and management of patients with inflammatory neuropathy and this warrants further studies,” the investigators concluded.
Find the full study in Annals of Clinical and Translational Neurology (doi: 10.1002/acn3.275).
FROM ANNALS OF CLINICAL AND TRANSLATIONAL NEUROLOGY
Malaria treatment, ACT effectiveness hampered by increased artemisinin resistance
Resistance to artemisinin in Plasmodium falciparum malaria increases the likelihood of spontaneous resistance to piperaquine, significantly reducing the effectiveness of artemisinin combination therapies, according to Dr. Chanaki Amaratunga and associates.
For the study, P. falciparum malaria patients were enrolled from three Cambodian provinces. In Pursat, where artemisinin resistance is common, 37 of 81 patients had parasite recrudescence; in Preah Vihear, where resistance is emerging, 10 of 63 patients had recrudescence; and in Ratanakiri, where resistance is rare, only 1 of 60 patients had recrudescence.
P. falciparum parasites that were recrudescent were about three times more likely to have kelch13 mutations than were nonrecrudescent parasites. Prevalence of kelch13 mutations were highest in Pursat at 77% during 2012-2013. Recrudescent parasites also had higher piperaquine IC50 values, lower mefloquine IC50 values, and did not have multiple pfmdr1 copies.
Patients with recrudescent parasites were more likely to have detectable piperaquine plasma levels at baseline, compared with patients with nonrecrudescent parasites, but did not differ significantly otherwise.
“Improvements in the treatment of P. falciparum malaria with real-time drug resistance data, identification and treatment of asymptomatic parasite carriers through community treatment campaigns, and prevention of gametocyte transmission to mosquitoes with single low-dose primaquine, are now needed more than ever if malaria elimination is to succeed in Southeast Asia,” the investigators concluded.
Find the full study in the Lancet Infectious Diseases (doi: 10.1016/S1473-3099[15]00487-9).
Resistance to artemisinin in Plasmodium falciparum malaria increases the likelihood of spontaneous resistance to piperaquine, significantly reducing the effectiveness of artemisinin combination therapies, according to Dr. Chanaki Amaratunga and associates.
For the study, P. falciparum malaria patients were enrolled from three Cambodian provinces. In Pursat, where artemisinin resistance is common, 37 of 81 patients had parasite recrudescence; in Preah Vihear, where resistance is emerging, 10 of 63 patients had recrudescence; and in Ratanakiri, where resistance is rare, only 1 of 60 patients had recrudescence.
P. falciparum parasites that were recrudescent were about three times more likely to have kelch13 mutations than were nonrecrudescent parasites. Prevalence of kelch13 mutations were highest in Pursat at 77% during 2012-2013. Recrudescent parasites also had higher piperaquine IC50 values, lower mefloquine IC50 values, and did not have multiple pfmdr1 copies.
Patients with recrudescent parasites were more likely to have detectable piperaquine plasma levels at baseline, compared with patients with nonrecrudescent parasites, but did not differ significantly otherwise.
“Improvements in the treatment of P. falciparum malaria with real-time drug resistance data, identification and treatment of asymptomatic parasite carriers through community treatment campaigns, and prevention of gametocyte transmission to mosquitoes with single low-dose primaquine, are now needed more than ever if malaria elimination is to succeed in Southeast Asia,” the investigators concluded.
Find the full study in the Lancet Infectious Diseases (doi: 10.1016/S1473-3099[15]00487-9).
Resistance to artemisinin in Plasmodium falciparum malaria increases the likelihood of spontaneous resistance to piperaquine, significantly reducing the effectiveness of artemisinin combination therapies, according to Dr. Chanaki Amaratunga and associates.
For the study, P. falciparum malaria patients were enrolled from three Cambodian provinces. In Pursat, where artemisinin resistance is common, 37 of 81 patients had parasite recrudescence; in Preah Vihear, where resistance is emerging, 10 of 63 patients had recrudescence; and in Ratanakiri, where resistance is rare, only 1 of 60 patients had recrudescence.
P. falciparum parasites that were recrudescent were about three times more likely to have kelch13 mutations than were nonrecrudescent parasites. Prevalence of kelch13 mutations were highest in Pursat at 77% during 2012-2013. Recrudescent parasites also had higher piperaquine IC50 values, lower mefloquine IC50 values, and did not have multiple pfmdr1 copies.
Patients with recrudescent parasites were more likely to have detectable piperaquine plasma levels at baseline, compared with patients with nonrecrudescent parasites, but did not differ significantly otherwise.
“Improvements in the treatment of P. falciparum malaria with real-time drug resistance data, identification and treatment of asymptomatic parasite carriers through community treatment campaigns, and prevention of gametocyte transmission to mosquitoes with single low-dose primaquine, are now needed more than ever if malaria elimination is to succeed in Southeast Asia,” the investigators concluded.
Find the full study in the Lancet Infectious Diseases (doi: 10.1016/S1473-3099[15]00487-9).
FROM THE LANCET INFECTIOUS DISEASES
Poor WM integrity tied to cognitive impairment in SPMS patients
Cognitive impairment in secondary progressive multiple sclerosis (SPMS) is linked to significantly worse white matter integrity in areas important to cognitive function, according to Dr. Kim A. Meijer and associates.
Compared with a control group of 32 healthy people, the 12 cognitively impaired and 18 cognitively preserved SPMS patients had significant loss of white matter integrity across the white matter skeleton. SPMS patients with cognitive impairment had more severe and extensive damage in several places, including the fornix, superior longitudinal fasciculus, and forceps major.
Poor cognitive function in SPMS patients was associated with lower premorbid IQ, female sex, and higher age. Combined with white matter integrity, these factors accounted for 48% of the difference in cognition between cognitively impaired and cognitively preserved SPMS patients.
“As with [relapsing remitting multiple sclerosis], damage to WM [white matter] tracts also appears to be a potential mechanism for cognitive impairment in SPMS patients. This study shows that the loss of WM integrity assessed using [tract-based spatial statistics] helps to explain cognitive decline and emphasizes the relevance of studying patterns of WM disruption throughout the brain in relation to cognitive deficits,” the investigators concluded.
Find the full study in the Multiple Sclerosis Journal (doi: 10.1177/1352458515622694).
Cognitive impairment in secondary progressive multiple sclerosis (SPMS) is linked to significantly worse white matter integrity in areas important to cognitive function, according to Dr. Kim A. Meijer and associates.
Compared with a control group of 32 healthy people, the 12 cognitively impaired and 18 cognitively preserved SPMS patients had significant loss of white matter integrity across the white matter skeleton. SPMS patients with cognitive impairment had more severe and extensive damage in several places, including the fornix, superior longitudinal fasciculus, and forceps major.
Poor cognitive function in SPMS patients was associated with lower premorbid IQ, female sex, and higher age. Combined with white matter integrity, these factors accounted for 48% of the difference in cognition between cognitively impaired and cognitively preserved SPMS patients.
“As with [relapsing remitting multiple sclerosis], damage to WM [white matter] tracts also appears to be a potential mechanism for cognitive impairment in SPMS patients. This study shows that the loss of WM integrity assessed using [tract-based spatial statistics] helps to explain cognitive decline and emphasizes the relevance of studying patterns of WM disruption throughout the brain in relation to cognitive deficits,” the investigators concluded.
Find the full study in the Multiple Sclerosis Journal (doi: 10.1177/1352458515622694).
Cognitive impairment in secondary progressive multiple sclerosis (SPMS) is linked to significantly worse white matter integrity in areas important to cognitive function, according to Dr. Kim A. Meijer and associates.
Compared with a control group of 32 healthy people, the 12 cognitively impaired and 18 cognitively preserved SPMS patients had significant loss of white matter integrity across the white matter skeleton. SPMS patients with cognitive impairment had more severe and extensive damage in several places, including the fornix, superior longitudinal fasciculus, and forceps major.
Poor cognitive function in SPMS patients was associated with lower premorbid IQ, female sex, and higher age. Combined with white matter integrity, these factors accounted for 48% of the difference in cognition between cognitively impaired and cognitively preserved SPMS patients.
“As with [relapsing remitting multiple sclerosis], damage to WM [white matter] tracts also appears to be a potential mechanism for cognitive impairment in SPMS patients. This study shows that the loss of WM integrity assessed using [tract-based spatial statistics] helps to explain cognitive decline and emphasizes the relevance of studying patterns of WM disruption throughout the brain in relation to cognitive deficits,” the investigators concluded.
Find the full study in the Multiple Sclerosis Journal (doi: 10.1177/1352458515622694).
FROM MULTIPLE SCLEROSIS JOURNAL